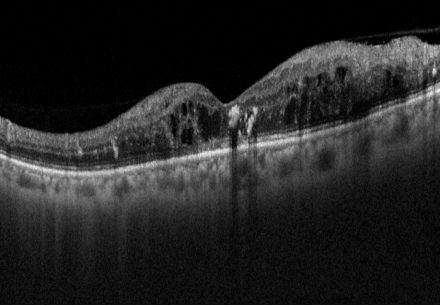

Oft lange keine. Später: unscharfes Sehen, schwarze Flecken, plötzliches „Rußregen“-Sehen → Notfall.
In der Augenpraxis Bergstraße nutzen wir modernste Netzhautdiagnostik, um diabetische Veränderungen frühzeitig zu entdecken und gezielt zu behandeln.
Die diabetische Retinopathie ist eine mikrovaskuläre Erkrankung der Netzhaut infolge von Diabetes mellitus. Sie führt durch langanhaltend erhöhte Blutzuckerwerte und andere Risikofaktoren zu Schädigungen kleiner Blutgefäße, Ablagerungen, Flüssigkeits- und Blutungseinlagerungen und kann unbehandelt in bestimmten Stadien das zentrale Sehen stark beeinträchtigen.

Keine diabetische Retinopathie

Diabetik Retinopati
Typische Merkmale sind:
Wichtig: Oft lange keine Beschwerden – daher ist die regelmäßige Vorsorge beim Augenarzt entscheidend.
• Langjähriger Diabetes mellitus (Typ 1 und Typ 2).
• Dauer und Kontrolle des Diabetes mellitus (Blutzuckerwerte, HbA1c).
• Schlechte Blutzuckereinstellung.
• Bluthochdruck, Gefäßgesundheit, Fettstoffwechselstörungen.
• Rauchen.
• Schwangerschaft bei bestehendem Diabetes (erhöhtes Risiko).
• Andere Faktoren wie Alter oder familiäre Belastung.
„Digitale Netzhautdiagnostik für höchste Sicherheit“
• Weitwinkel-Aufnahme des Augenhintergrundes – dokumentiert große Bereiche der Netzhaut in einer einzigen Aufnahme. Ideal zur Erfassung diabetischer Gefäßveränderungen und peripherer Netzhautbefunde. In vielen Fällen ohne pupillenerweiternde Tropfen möglich – das bedeutet für Sie: bequeme Untersuchung und in der Regel anschließend selbst Auto fahren.
• SD-OCT (Spektral-Domain-OCT) hochauflösende Schnittbilder der Netzhaut zur frühzeitigen Erkennung von Flüssigkeitseinlagerungen, Makulaödemen oder strukturellen Veränderungen
• Fluoreszenzangiographie – Darstellung der Netzhautdurchblutung nach Farbstoffgabe, um Gefäßleckagen, Durchblutungsstörungen oder neue Gefäßbildungen sichtbar zu machen.
• Fundusfotografie & Autofluoreszenz – zur Dokumentation und Verlaufskontrolle von Stoffwechsel- und Zellveränderungen in der Netzhaut.
• Gesichtsfeld- und Sehschärfetests – ergänzen die bildgebende Diagnostik durch funktionelle Messungen des Sehens.
Normalbefund der SD-OCT

Diabetisches Makulaödem
Ihre Vorteile:
• Frühzeitige Erkennung kleinster Veränderungen – bevor Beschwerden auftreten.
• Digitale Dokumentation – alle Befunde werden gespeichert und können objektiv im Verlauf verglichen werden.
• Leitliniengerechte Standards – Diagnostik erfolgt nach Empfehlungen der Fachgesellschaften.
• Patientenkomfort – viele Verfahren sind schmerzfrei und ohne Pupillenerweiterung möglich.
Die Behandlung der diabetischen Retinopathie richtet sich nach dem Stadium der Erkrankung und wird individuell an Ihren Befund angepasst. Ziel ist es, das Sehvermögen möglichst lange zu erhalten und Komplikationen zu verhindern.
Unsere Therapieansätze:
• Systemische Basis: Eine gute Einstellung von Blutzucker, Blutdruck und Blutfetten ist die Grundlage, um das Fortschreiten der Erkrankung zu verlangsamen. Intravitreale Injektionen (IVOM): Bei diabetischem Makulaödem kommen Medikamente (Anti-VEGF oder Steroide) direkt ins Auge zur Anwendung. Sie zielen auf die Rückbildung der Flüssigkeit und eine Stabilisierung des Sehens.
• Laserkoagulation:
• Fokal bei einzelnen undichten Gefäßen.
• Panretinal (PRP) bei proliferativer Retinopathie, um schwere Blutungen oder Netzhautablösungen zu verhindern.
• Operation (Vitrektomie): Bei Glaskörperblutungen oder traktionaler Netzhautablösung kann eine Operation notwendig sein.
Ziel: Sehvermögen erhalten und Komplikationen verhindern – nicht Heilung, sondern Kontrolle der Erkrankung.
• Digitale High-End-Diagnostik: Hochauflösende dreidimensionale SD‑OCT kombiniert mit simultaner cSLO-Fundusbild.
• Weitwinkel-Bildgebung des Augenhintergrunds.
• Individuelle Betreuung: Jede Therapieentscheidung basiert auf Ihrem Gesamtbild (Befund, Diabetes-Einstellung, Risikofaktoren).
• Enge Kooperation: Wir stimmen uns bei Bedarf eng mit Ihrem Hausarzt/Diabetologen
• Langfristige Begleitung: Chronische Erkrankung = regelmäßige Kontrollen mit klar strukturiertem Plan.
Nein – aber durch gute Einstellung des Diabetes und rechtzeitige augenärztliche Therapien lässt sich das Fortschreiten deutlich bremsen.
Mindestens 1x jährlich, bei Auffälligkeiten oder insulinpflichtigem Diabetes auch häufiger.
Oft lange keine. Später: unscharfes Sehen, schwarze Flecken, plötzliches „Rußregen“-Sehen → Notfall.
Ja. Die Basisdiagnostik bei Diabetes (z. B. Netzhautkontrolle mit der Spaltlampe, Fundusuntersuchung) ist eine Kassenleistung. Erweiterte Verfahren wie die Weitwinkel-Bildgebung oder zusätzliche OCT-Untersuchungen gehören in der Regel nicht zum Leistungskatalog der gesetzlichen Krankenkassen und werden daher als Individuelle Gesundheitsleistungen (IGeL) angeboten – wir klären Sie vorher transparent auf.
Unbehandelt drohen Blutungen, Netzhautablösung und im schlimmsten Fall Erblindung.
Nein – aber durch gute Einstellung des Diabetes und rechtzeitige augenärztliche Therapien lässt sich das Fortschreiten deutlich bremsen.
Mindestens 1x jährlich, bei Auffälligkeiten oder insulinpflichtigem Diabetes auch häufiger.
Oft lange keine. Später: unscharfes Sehen, schwarze Flecken, plötzliches „Rußregen“-Sehen → Notfall.
Ja. Die Basisdiagnostik bei Diabetes (z. B. Netzhautkontrolle mit der Spaltlampe, Fundusuntersuchung) ist eine Kassenleistung. Erweiterte Verfahren wie die Weitwinkel-Bildgebung oder zusätzliche OCT-Untersuchungen gehören in der Regel nicht zum Leistungskatalog der gesetzlichen Krankenkassen und werden daher als Individuelle Gesundheitsleistungen (IGeL) angeboten – wir klären Sie vorher transparent auf.
Unbehandelt drohen Blutungen, Netzhautablösung und im schlimmsten Fall Erblindung.
Qualität, Sorgfalt und persönliche Nähe sind die Grundlage unserer Arbeit – für Ihr bestes Sehen, heute und in Zukunft
Kostenfreie Patienten-Parkplätze
